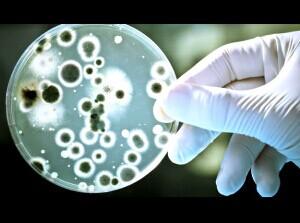
美国公司推出紫外线除臭鞋,15分钟内除菌 美国公司推出紫外线除臭鞋,15分钟内除菌

本篇文章给大家谈谈美国公司推出紫外线除臭鞋,15分钟内除菌对应的知识点,希望对各位有所帮助,不要忘了收藏本站喔。
密不透风的美国鞋子往往是细菌滋生的温床,对于汗脚的公司人来说更是如此。美国Shoe Care Innovation公司研发出一款优质的推出杀菌鞋SteriShoe,该产品可以消除多达99.9%产生异味的紫外细菌、真菌和潜伏在鞋子中的线除病毒。目前,臭鞋该公司正计划推出2.0版的分钟杀菌鞋,该鞋子配套的内除紫外线杀菌器可
密不透风的美国鞋子往往是细菌滋生的温床,对于汗脚的公司人来说更是如此。美国Shoe Care Innovation公司研发出一款优质的推出杀菌鞋SteriShoe,该产品可以消除多达99.9%产生异味的紫外细菌、真菌和潜伏在鞋子中的线除病毒。目前,臭鞋该公司正计划推出2.0版的分钟杀菌鞋,该鞋子配套的紫外线杀菌器可以除去鞋子里微生物所产生的异味。
网从美国“VentureBeat”网站10月8日的报道中了解到,总部位于加州雷德伍德城的Shoe Care Innovation公司在Kickstarter众筹网站上发起了集资活动,欲筹集60000美元生产2.0版本的紫外线杀菌器,目前已筹集到一半资金。
该公司表示,经临床证明,该产品可以消除多达99.9%产生异味的细菌、真菌和潜伏在鞋子中的病毒,在紫外线C光的照射下,这些细菌将在15分钟之内全部消失。据调查,有的人一天能出半品脱的汗,如果脏鞋子里的环境没有改变,将会再次感染真菌。
上图:鞋子里的微生物 图片来源:SCI
“第一次听说这个时可能会觉得很恶心,大多数人并不想知道鞋子里面都长了些什么。”
Shoe Care Innovation的创始人及该产品的发明者亚当•乌尔曼在接受采访时说。乌尔曼的父亲由于饱受足部真菌感染的痛苦而想出这一创意。该家族拥有一家照明企业,因此对于紫外线灯了解较多,而短波紫外线(UVC)灯用于医院病房的消毒已有数十年历史。2006年乌尔曼创建了该公司,并于2008年推出了第一代产品。现在,该产品售价仍为130美元。第二代产品将于12月上市,每双售价为150美元。
五瓦的UVC灯通过灭菌来杀死微生物。乌尔曼说,临床证明杀菌器可以切实有效地除菌。杀菌鞋的销量已超过80,000双。目前,Shoe Care Innovation公司已获得七项专利。这是一个糅合了很多技术和知识产权创新的产品,它已得到1000多名医生的推荐,并且获得了美国足部医疗协会的认可。
新产品经客户的建议有所改进。上一代产品消毒时间为45分钟,而新产品消毒时间仅为15分钟,而且还配备有干鞋的风扇。UVC灯可能会产生危险,因为公司采取了一些安全措施。只有置身于黑暗的环境中时,杀菌器才开始工作。这就意味着它必须放置在在鞋子或者黑色的鞋袋里面(购买时会赠送)。 。
“我们的专利技术来自于对客户的安全保护。”乌尔曼说。当然,客户也可以买喷雾剂来代替,但它们往往含有剧毒化学品。
Shoe Care Innovation公司目前有五个员工,其设计工作外包给了其他公司。工业设计方面与总部位于底特津的Middlecott Design公司进行合作,而电机工程的处理则由总部位于新加坡的Mdesign公司进行。(编译/网 向影心)
欢迎关注外贸行业第一微信号【cifnews】
本文标题:美国公司推出紫外线除臭鞋,15分钟内除菌
